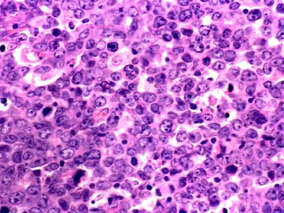
R-CHOP治疗后完全缓解的DLBCL患者仍有较大的复发风险

-
依鲁替尼单药治疗复发/难治MCL疗效持久且安全性良好
环球医学资讯
2015年09月21日
点击量:312
1小时条评论由于套细胞淋巴瘤(MCL)目前仍没有确切的可治愈方案,大部分患者将复发进展,或发展为难治性病例。2015年8月,发表于《Blood》的一项研究考察了依鲁替尼单药治疗复发或难治MCL的安全性和有效性。结果显示,随着随访期延长,继续证明依鲁替尼治疗复发/难治MCL患者的...
-
口服抗肿瘤药物:我们怎样考虑依从性问题?
环球医学资讯
2015年09月09日
点击量:340
1小时条评论口服药物治疗,包括基于激素的治疗或靶向治疗,最近在癌症治疗中已经占有一席之地。但成年患者对口服抗肿瘤药物治疗的依从性问题值得研究。2015年8月,发表在《Br J Clin Pharmacol》的一篇文章对口服抗肿瘤药物治疗的依从性进行了综述。 目的:口服药物治疗,包括...
-
辛伐他汀对子宫肌瘤治疗是否有效?
环球医学资讯
2015年08月26日
点击量:123
1小时条评论子宫肌瘤是常见的妇科疾病,长期药物治疗效果不令人满意。在2015年8月,发表在《Am J Obstet Gynecol.》的一篇研究表明,辛伐他汀或可有效治疗子宫肌瘤。 目的:子宫肌瘤是常见的妇科疾病,长期药物治疗效果不令人满意。本研究观察辛伐他汀在体内与体外实验中对子宫...
-
二甲双胍可改善食道癌患者总生存期和无远处转移生存率
环球医学资讯
2015年08月21日
点击量:696
1小时条评论近期研究显示,二甲双胍使用与食道癌患者癌症发病率降低和预后改善相关。2015年6月发表在《Eur J Surg Oncol.》的一项荷兰研究在一个由因食道癌而接受治疗的患者组成的单一机构队列中进行,探究了二甲双胍使用与结局(病理学应答率、无远处转移和总生存期)的关系。 ...
-
R-CHOP治疗后完全缓解的DLBCL患者仍有较大的复发风险
环球医学资讯
2015年08月21日
点击量:394
1小时条评论弥漫性大B细胞淋巴瘤(DLBCL)是成人最常见的非霍奇金淋巴瘤(NHL),约占全部NHL的30~40%。2015年7月发表在《Br J Haematol.》的一项荷兰研究表明,R-CHOP治疗后完全缓解的DLBCL患者仍有较大的复发风险。 nbsp; 本研究采用系统评价方法,研究在接受利妥昔单抗、环...
-
ABVD用于老年经典型霍奇金淋巴瘤患者的有效性和毒性
环球医学资讯
2015年08月21日
点击量:604
1小时条评论放疗和化疗的应用使霍奇金淋巴瘤成为可治愈性肿瘤,但可引起不育以及畸形等。2015年7月发表在《Br J Haematol》的一项法国研究,探究了ABVD用于老年经典型霍奇金淋巴瘤患者的有效性和毒性。 nbsp; 没有经典型霍奇金淋巴瘤(cHL)老年患者的标准疗法。对于年轻患者...
-
血液恶性肿瘤患者中泊沙康唑缓释片的血药浓度高于混…
环球医学资讯
2015年08月19日
点击量:785
1小时条评论2015年8月,发表于《Antimicrob Agents Chemother》的一篇文章比较了血液恶性肿瘤患者使用泊沙康唑混悬剂和缓释片预防侵袭性真菌疾病的血药浓度。结果显示,缓释片的血药浓度优于混悬剂。 nbsp; 泊沙康唑(PCZ),可用于高风险患者侵袭性真菌疾病的预防,市场上用...
-
CODOX-M/IVAC-利妥昔单抗调整方案可安全有效治疗HIV…
环球医学资讯
2015年08月19日
点击量:2063
1小时条评论2015年7月,发表于《Blood》的一篇文章介绍了HIV相关淋巴瘤的治疗新方案。调整后CODOX-M/IVAC-利妥昔单抗当可安全有效地治疗HIV相关淋巴瘤。 nbsp; 关键点:我们报告了首个HIV-淋巴瘤治疗方案有效性与安全性的多中心前瞻性研究。 nbsp; 通过修改现有的方案,提供...
-
华法林引起癌症患者肢体静脉缺血性坏死的病例报道和…
环球医学资讯
2015年08月19日
点击量:457
1小时条评论肢体静脉缺血性坏死(VLG)是华法林一个罕见而严重的不良反应。2015年7月,发表在《Blood》上的一项研究显示,使用华法林后癌症患者肢体静脉缺血/坏死可部分由凝血-抗凝血平衡严重受损所解释。 nbsp; 癌症患者会发生肢体静脉缺血性坏死(VLG),但其临床表现和发病...
-
依维莫司对复发性T细胞淋巴瘤具有体外抗肿瘤活性
环球医学资讯
2015年08月19日
点击量:430
1小时条评论2015年7月,发表于《Blood》的一篇文章考察了复发性T细胞淋巴瘤患者中,mTORC1抑制剂依维莫司的体外及体内抗肿瘤活性。结果显示,依维莫司对于T细胞淋巴瘤细胞具有抗肿瘤活性,并在患者身上产生抗肿瘤效应。 nbsp; 关键点:mTOR通路在TCL细胞中具有结构活性,并负...

会员登录

